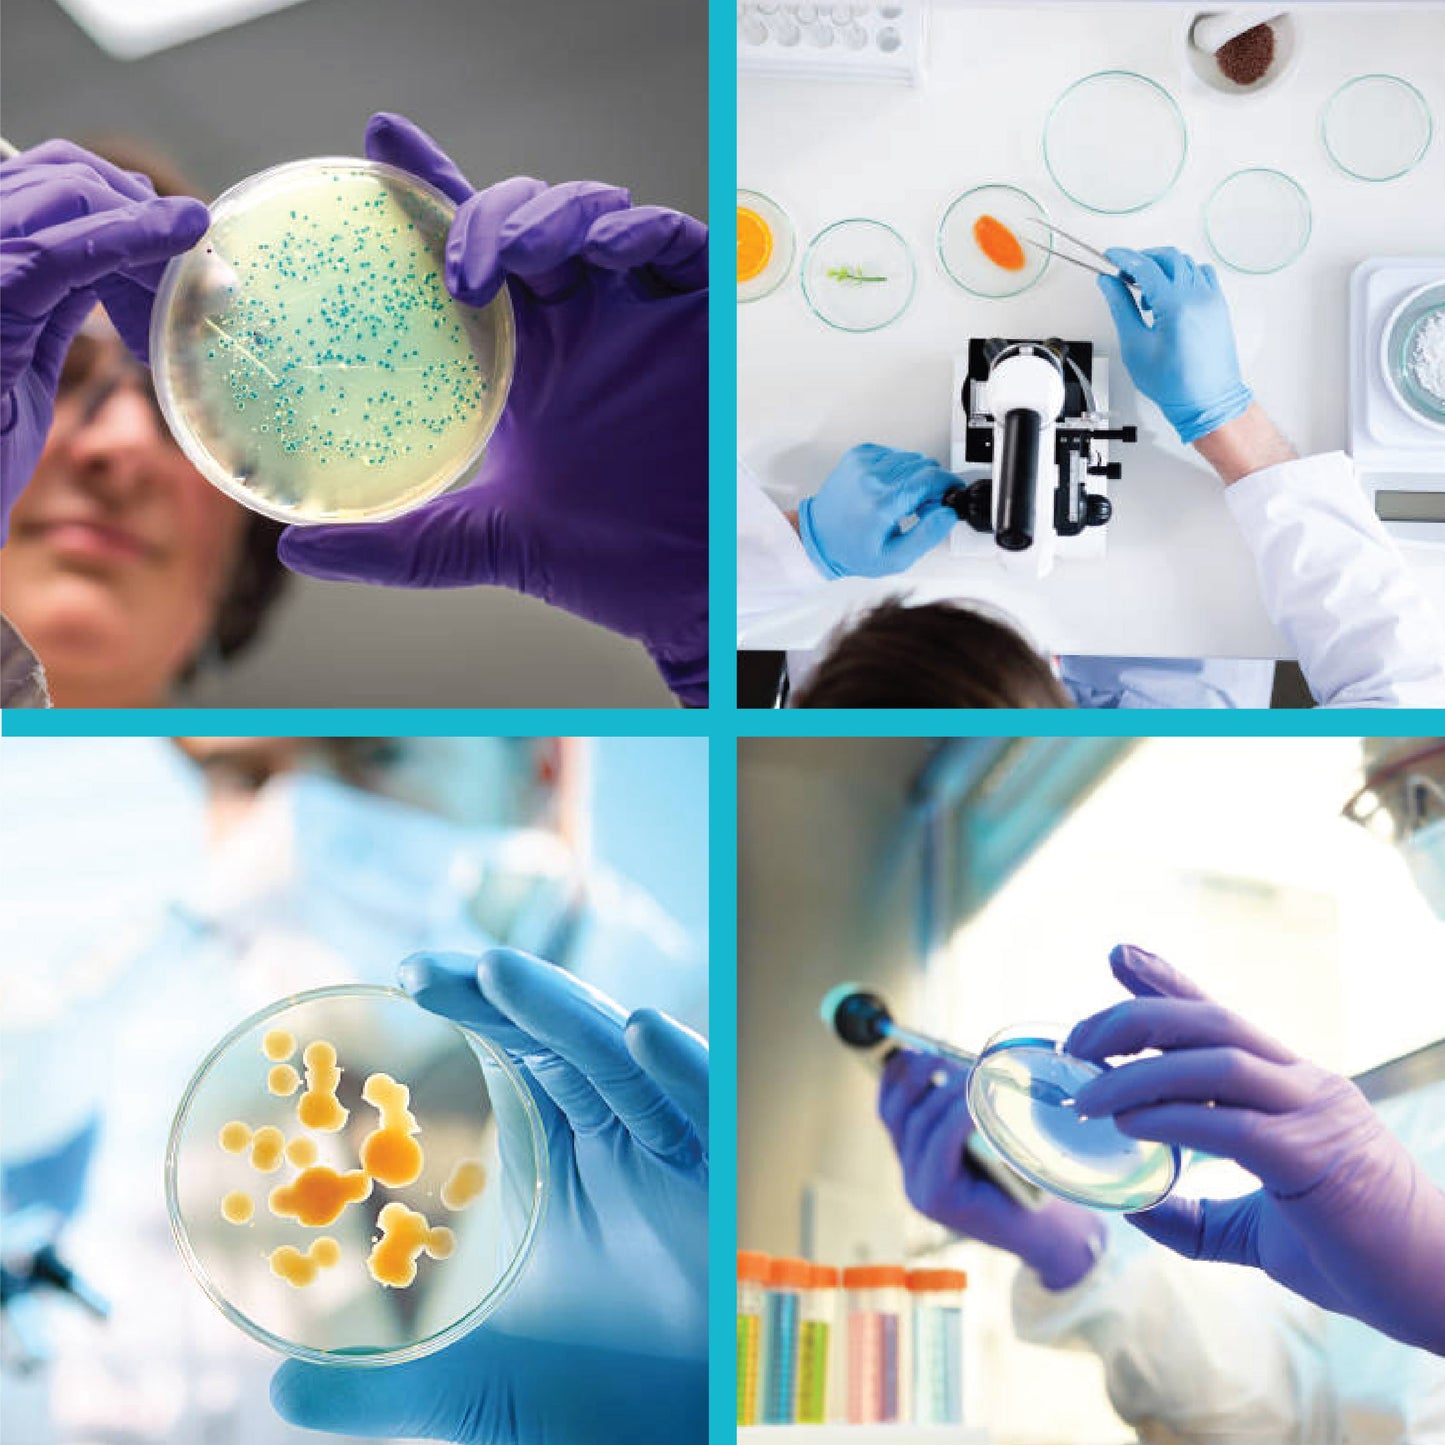
Labglass by EISCO - Premium Petri Dish, Heavy Borosilicate Glass 3.3, Can Withstand Wet or Dry Repeated Sterilisation, Beaded Edges for Strength (150 X 25 mm, Pack of 2)

1
/
of
7
labzio
Labglass by EISCO - Premium Petri Dish, Heavy Borosilicate Glass 3.3, Can Withstand Wet or Dry Repeated Sterilisation, Beaded Edges for Strength (150 X 25 mm, Pack of 2)
Labglass by EISCO - Premium Petri Dish, Heavy Borosilicate Glass 3.3, Can Withstand Wet or Dry Repeated Sterilisation, Beaded Edges for Strength (150 X 25 mm, Pack of 2)
SKU:CH0368F/PK2
Regular price
Rs. 699.00
Regular price
Rs. 1,426.97
Sale price
Rs. 699.00
Unit price
/
per
Tax included.
Couldn't load pickup availability
- Heavy duty borosilicate glass petri dish
- Autoclavable, can withstand direct flames and harsh chemicals
- Can withstand wet or dry repeated sterilization
- Beaded edges for greater mechanical strength
- 150mm dia, 25 mm height
Share